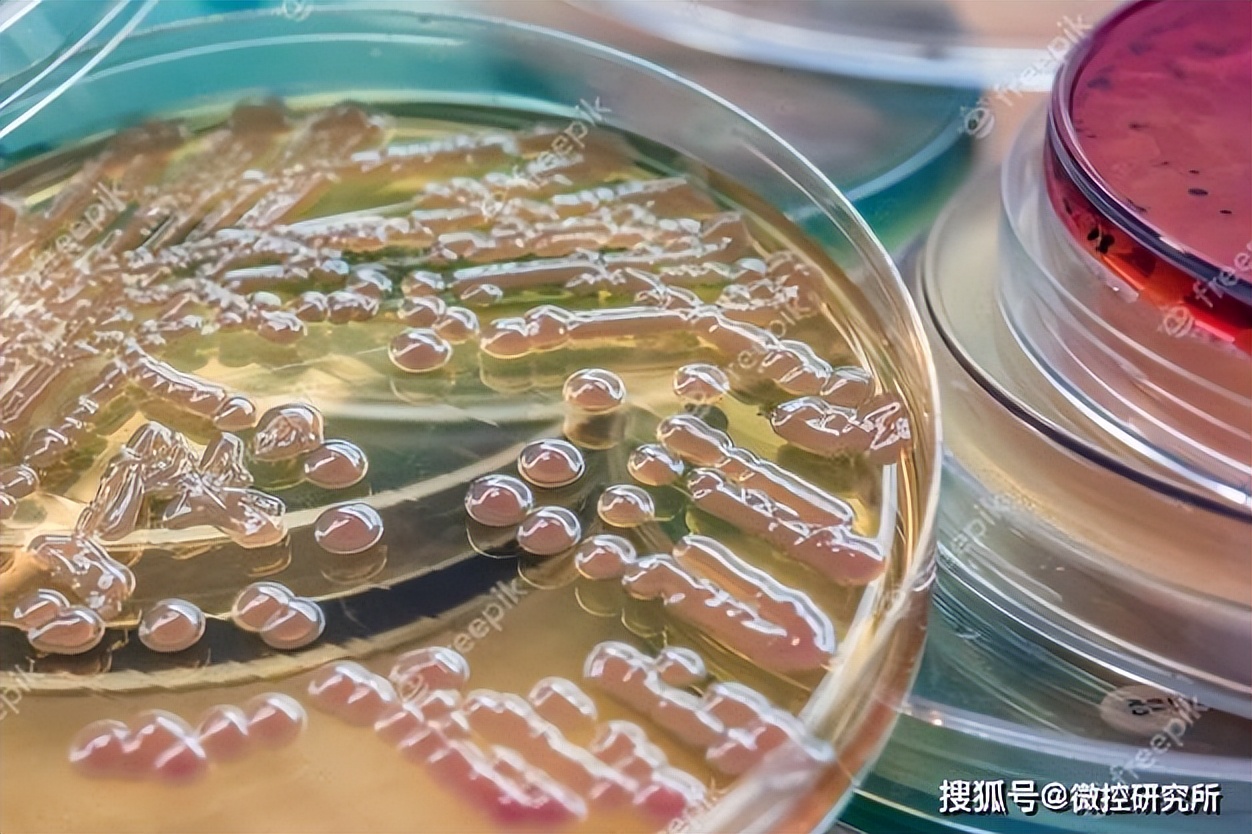
食品中菌落总数实验步骤完整视频,食品菌落超标一般都是什么原因
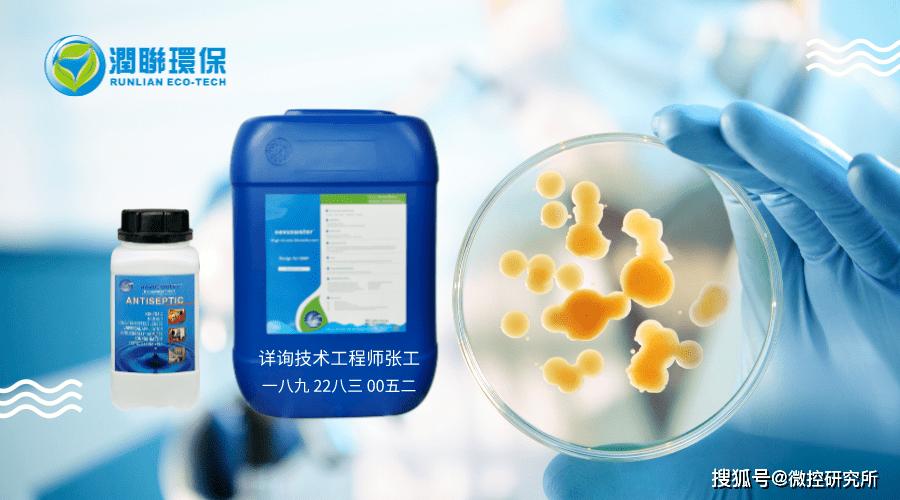
食品中菌落总数实验步骤完整视频,食品菌落超标一般都是什么原因

随着人们日常食品安全意识的提高,越来越关注食品健康问题,但是食品菌落总数超标等新闻报道却屡见不鲜,涉及到食品的各个领域,熟食肉类产品,糕点类,甚至是桶装水都检测出食品菌落总数超标达到上百倍。
菌落是指细菌在固体培养基上生长繁殖而形成的能被肉眼识别的生长物,它是由数以万计相同的细菌集合而成。菌落总数就是指在一定条件下每克(每毫升)检样所生长出来的细菌菌落总数。一般反映食品在生产、储存、销售过程中的卫生措施和管理情况。利用菌落总数可预测食品的耐保存性。在中国和许多国家的食品卫生标准中,都有规定了各类食品菌落总数的标准。
从卫生角度来说,超过了菌落总数标准,就会被列入卫生不合格产品。如果菌落总数超标严重,可能会造成腹泻。
食品的菌落超标的危害:
1、会破坏食物的营养成分
2、加速食品的腐败变质
3、超标严重食用后可使人患上肠道疾病 危害人体健康。
菌落总数并不都是致病菌,菌落总数包括致病菌和有益菌,其中的致病菌,会对人体造成危害,当其进入人体后会破坏肠道里正常的菌落环境,引起腹泻、损伤肝脏等身体器官,菌落总数超标也意味着致病菌超标的机会增大,增加危害人体健康的几率。
食品菌落总数超标的原因:
1生产环节,生产加工环节原辅料、人员、设备、环境受到污染和消毒不彻底导致,将细菌带入食品中,导致菌落总数超标。
2冷却包装环节,在冷却、内包装过程中,遭受空气中细菌二次污染,从而导致食品菌落总数含量超标。
3运输储存环节, 加工包装后由于运输储存环节消毒和冷藏环节不完善,导致细菌爆发。
食品菌落总数超标问题日益严重,而最主要的源头还是食品生产企业的消毒灭菌不完善导致的,而食品企业在选择灭菌产品时,最关心的莫过于高效灭菌,安全无害,操作简单快捷这些问题。而诺福novuswater的出现大大解决了食品企业的后顾之忧。
诺福novuswater,采用比利时先进技术,全球最纯净的杀菌,消毒,防腐剂,目前已广泛应用于欧洲大陆,其合作伙伴包括,欧洲上千家食品企业,荷兰大部分的饮用水企业、比利时可口可乐公司、英国国家饮用水部门,苏格兰饮用水部门以及德国、比利时等近千家单位、机构、公司,并且诺福novuswater已经进入中国十年对国内的食品安全问题有着丰富的经验与解决方案。
诺福novuswater特点:
1.高效广谱杀菌效果,可灭杀有害菌以及有害微生物种类包括:造成禽流感的Influenza A Virus、大肠杆菌、军团菌属、阿米巴菌、黄色葡萄球菌、大肠埃希氏菌、等在内的200多种的细菌、真菌、微生物等。
2.消毒杀菌能力极强、空间消毒灭菌、表面消毒灭菌效果显著,并且在使用后可以抑制各种微生物、细菌及霉菌的滋生和生长。长期使用,细菌不会产生耐药性。
3.无色、无毒、无异味、无残留、不起沫、完全溶于水,发生反应后仅剩余氧气和水真正的无污染、消毒结束后不需要再次冲洗,无残留物,用诺福novuswater消毒后,不需要再用清水清洗,节省了消毒成本,同时节约了水资源。
4.稳定性极强,作用时间长,效果明显,能完全杀死有害菌,应用弹性大,对光照的依赖程度为0,不受温度和PH值的影响不易挥发,完全环保。
诺福novuswater已经进入中国十个年头,期间已经服务了数千家客户,在食品灭菌行业有着非常丰富的经验,并能根据企业的不同特性,提供最完美的解决方案,如有需要,欢迎联系。